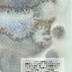

小さいお絵描き
- Digital100 JPY








創作同人電子書籍
「落書きというには気合いが入りすぎているが…」
金色の絵の具が綺麗だと感じて使いまくった。紙の上の水彩絵の具に光にあたるキラキラを見たかった。筆任せにスケッチブックに描き散らかした。 あくまでも気楽に描いているお絵描きの記録保存用にPCに用意したフォルダの名前が「小さいお絵描き」。その中のアナログで描いた絵を中心にまとめたイラスト画集。2026年1月の関西COMITIA75にて「乱痴気事虫所」より発行の自主出版誌を電子書籍化。第30回いっせい配信「創作同人2026年3月」 参加作品。 data format pdf :18.0MB epub :17.9MB (全年齢向け:本文フルカラー:20p) 電子書籍出版元: まるかふぇ電書
See More